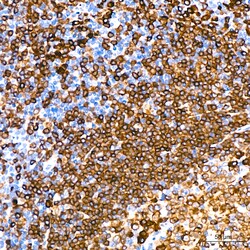
Invitrogen CD79a Recombinant Rabbit Monoclonal Antibody (3G10U6) 100 &mu;L;

missing translation for 'onlineSavingsMsg'
Learn More
Learn More
Invitrogen™ CD79a Recombinant Rabbit Monoclonal Antibody (3G10U6)


Rabbit Recombinant Monoclonal Antibody
Brand: Invitrogen™ MA535209
This item is not returnable.
View return policy
Description
Immunogen sequence: MPGGPGVLQA LPATIFLLFL LSAVYLGPGC QALWMHKVPA SLMVSLGEDA HFQCPHNSSN NANVTWWRVL HGNYTWPPEF LGPGEDPNGT LIIQNVNKSH.
CD79a is a disulphide-linked heterodimer that includes B29 (CD79b) polypeptide. CD79a is a B lymphocyte antigen receptor with an antigen-specific surface component Ig (immunoglobulin) that associates with Ig-alpha and Ig-beta, necessary elements for the expression and function of the B-cell antigen receptor. CD79a first appears at pre-B cell stage and persists until the plasma cell stage where it is found as an intracellular component. CD79a is found in the majority of acute leukemias of precursor B cell type, in B cell lines, B cell lymphomas, and in some myelomas. It is not present in myeloid or T cell lines. Diseases associated with CD79a include Agammaglobulinemia 3 and Agammaglobulinemia, Non-Bruton type.
Specifications
| CD79a | |
| Recombinant Monoclonal | |
| 1.0 mg/mL | |
| PBS with 0.05% BSA, 50% glycerol and 0.02% sodium azide; pH 7.3 | |
| P11912 | |
| CD79A | |
| Synthetic peptide. | |
| 100 μL | |
| Primary | |
| Human | |
| Antibody | |
| IgG |
| ELISA, Immunohistochemistry (Paraffin), Western Blot | |
| 3G10U6 | |
| Unconjugated | |
| CD79A | |
| B-cell antigen receptor; B-cell antigen receptor complex-associated protein alpha chain; B-cell antigen receptor complex-associated protein alpha chain-like; CD79; CD79a; CD79A antigen (immunoglobulin-associated alpha); CD79a molecule; CD79a molecule, immunoglobulin-associated alpha; CD79A protein; CD79-alpha protein; EGK_10665; Ig alpha; IGA; Igalpha; ig-alpha; immunoglobulin-associated alpha; LOC100913063; Ly54; Ly-54; MB1; MB-1; MB-1 membrane glycoprotein; Membrane-bound immunoglobulin-associated protein; surface IgM-associated protein | |
| Rabbit | |
| Affinity Chromatography | |
| RUO | |
| 973 | |
| -20°C, Avoid Freeze/Thaw Cycles | |
| Liquid |
Product Content Correction
Your input is important to us. Please complete this form to provide feedback related to the content on this product.
Product Title
Spot an opportunity for improvement?Share a Content Correction